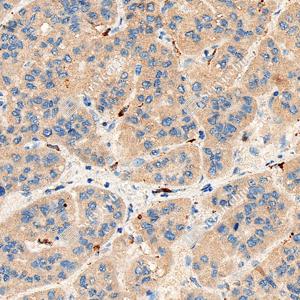

Recombinant Anti-4 Hydroxynonenal antibody (Mouse mAb)
- 100 μL
产品信息
|
别名 |
4-HNE |
|
抗体亚型 |
IgG1 |
|
克隆号 |
SB407 |
|
纯化方式 |
亲和纯化 |
|
亚细胞定位 |
细胞质 |
应用
| 应用 | 物种 | 稀释 | 阳性样品 |
| IHC/IF 免疫组织化学/免疫荧光 | Species independent | 1: 500-1: 1000 | 肝癌, 阿尔茨海默症脑组织模型, 非酒精性脂肪肝 |
背景
4-Hydroxynonenal (4-HNE) is an α,β unsaturated hydroxyalkenal and an oxidative/nitrosative stress biomarker. 4-Hydroxynonenal is a substrate and an inhibitor of acetaldehyde dehydrogenase 2 (ALDH2). 4-Hydroxynonenal can modulate a number of signaling processes mainly through forming covalent adducts with nucleophilic functional groups in proteins, nucleic acids, and membrane lipids. 4-Hydroxynonenal plays an important role in cancer through mitochondria.
图像
|
|
IHC analysis of 4 Hydroxynonenal(GB150073). Sample: Human liver cancer, 4% PFA (G1101) 12-24h. Antigen retrieval: Tris-EDTA buffer (pH 9.0) (G1203), 98℃, 20min. Primary antibody: 1: 500, 4℃ overnight. Secondary antibody: S-vision poly-HRP conjugated Goat Anti-Mouse lgG (H+L), Ready to use(G1301), RT, 20min. |
|
|
IHC analysis of 4 Hydroxynonenal(GB150073). Sample: Mouse model of Alzheimer's brain , 4% PFA (G1101) 12-24h. Antigen retrieval: Tris-EDTA buffer (pH 9.0) (G1203), 98℃, 20min. Primary antibody: 1: 500, 4℃ overnight. Secondary antibody: S-vision poly-HRP conjugated Goat Anti-Mouse lgG (H+L), Ready to use(G1301), RT, 20min. |
|
|
IHC analysis of 4 Hydroxynonenal(GB150073). Sample: Mouse model of Alzheimer's brain , 4% PFA (G1101) 12-24h. Antigen retrieval: Tris-EDTA buffer (pH 9.0) (G1203), 98℃, 20min. Primary antibody: 1: 500, 4℃ overnight. Secondary antibody: S-vision poly-HRP conjugated Goat Anti-Mouse lgG (H+L), Ready to use(G1301), RT, 20min. |
|
|
IHC analysis of 4 Hydroxynonenal(GB150073). Sample: Mouse Non-alcoholic fatty liver , 4% PFA (G1101) 12-24h. Antigen retrieval: Tris-EDTA buffer (pH 9.0) (G1203), 98℃, 20min. Primary antibody: 1: 500, 4℃ overnight. Secondary antibody: S-vision poly-HRP conjugated Goat Anti-Mouse lgG (H+L), Ready to use(G1301), RT, 20min. |
|
|
IHC analysis of 4 Hydroxynonenal(GB150073). Sample: Mouse subcutaneous tumor of Panc4 cell , 4% PFA (G1101) 12-24h. Antigen retrieval: Tris-EDTA buffer (pH 9.0) (G1203), 98℃, 20min. Primary antibody: 1: 500, 4℃ overnight. Secondary antibody: S-vision poly-HRP conjugated Goat Anti-Mouse lgG (H+L), Ready to use(G1301), RT, 20min. |
储存
| 储存条件 | 在-20℃下储存一年, 避免反复冻融. |
| 储存缓冲液 | 含0.15% ProClin300防腐剂, 100 μg/mL牛血清白蛋白和50%甘油的磷酸盐缓冲液. |
注意:
1.本产品仅供研究使用.
2.建议用一抗稀释液(G2025)稀释本产品.
| 货号 | 名称 | 规格 | 价格 | 操作 |
|---|
| 货号 | 名称 | 规格 | 价格 | 操作 |
|---|